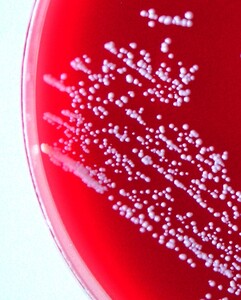

Introduction
Staphylococcus warneri is a gram-positive, coagulase-negative, catalase-positive and oxidase-negative bacterium, and a member of the bacterial genus Staphylococcus and Staphylococcaceae family. The first isolation of S. warneri from diseased rainbow trout broodstock was reported by Gil et al. (2000) in northwest Spain and, later, by Metin et al. (2014) in Turkey. In pure culture S. warneri was also isolated in Coreius guichenoti (Xiao et al. 2022). Co-infections with S. warneri and Shewanella putrefaciens were previously reported in Siberian sturgeon (Acipenser baerii) and hybrid sturgeon (Huso × Acipenser baerii) by Rusev et al. (2016) and co-infections with Aeromonas salmonicida, Carnobacterium maltaromaticum and Flavobacterium oncorhynchi were reported in koi carp by Řehulka et al. (2020).
In this study, the authors describe the first isolation and characterisation of Staphylococcus warneri from diseased rainbow trout broodstock in raceway culture system in Czech Republic. We recorded the clinical and microscopical signs in the affected fish and unusual lesions of the observed peripheral erythrocytes.
Materials and methods
Fish collection
Spontaneous infection was found in rainbow trout broodstock in raceway culture where the fish were kept in a concrete tank (8 × 0.8 × 0.8 m) at a density of 110 kg m-3 and the water had the following physical and chemical characteristics: temperature 7–9 °C, dissolved O2 10.1–11 mg L-1, pH 7.1–7.3, total hardness 4.8–5 °N, chemical oxygen demand (CODMn) 2.8–3.2 mg L-1, nitrites (NO2-) 0.051–0.067 mg L-1 , nitrates (NO3-) 5.7–6.9 mg L-1 and ammonium (NH4+) 0.14–0.38 mg L-1. The examined fish had a standard length of 100–115 mm and were fed dry pelleted feed containing 40 % crude protein (N × 6.25) and 14 % crude fat. Ten affected fish and ten fish without clinical signs were subjected to clinical, necropsy, parasitological, bacteriological and haematological examination.
Bacteriology
Bacteriological procedures consisted of the preparation and Gram staining of tissue smears, inoculation of growth media and evaluation of microbial cultures. Swab samples from fish were streaked on blood agar (MKM 01011; Columbia agar; Trios) (BA), tryptic soya agar (MKM 10061; Trios) (TSA) and cytophaga agar (Pacha and Ordal 1967). Plates were then incubated at 22 °C. Wet mounts of infected tissue from external lesions were checked under microscope (×100 magnification).
Culture and phenotypic identification of the bacterial strains
The staphylococcal strains were characterised using STAPHYtest 24 (Erba Lachema, Czech Republic) and ErbaExpert software (Erba Lachema, Czech Republic) according to the manufacturer’s instructions. The complementary conventional biochemical, physiological and growth tests relevant for the genus Staphylococcus were performed as described by Pantůček et al. (2013). The production of alpha-, beta- and delta-haemolysins was screened, based on either synergy or antagonism with beta haemolysin of the S. pseudintermedius standard strain CCM 4710 on blood agar plates in mixed atmosphere, according to Hébert and Hancock (1985). Antimicrobial susceptibility testing was performed by disk diffusion method based on MH-agar and ATB disk (ThermoFisher Scientific) with adherence to EUCAST (version 15.0, valid from 2025-01-01).
The genes for Panton-Valentine leukocidin, staphylococcal enterotoxin SEA –SED, exfoliative toxins ETA, ETB and ETD, toxic shock syndrome toxin TSST-1, and mecA gene were screened using polymerase chain reaction (PCR) or multiplex PCR.
MALDI-TOF mass spectrometry identification
Matrix-assisted laser-desorption/ionisation time-of-flight mass spectrometry Microflex LT (Bruker Daltonics, Germany) was also used for identification. Mass spectra were processed using BioTyper software (version 3.1; Bruker Daltonics) supplemented with database version MBT Compass Library Revision K (2022).
Molecular identification
The results of phenotypic identification and MALDI-TOF mass spectrometry identification were verified by Sanger sequencing. Total DNA was isolated using QIAamp DNA Mini Kit (Qiagen, DE) according to the instructions of the manufacturer. 16S rDNA fragment was PCR-amplified using primers PSL for: AGGATTAGATACCCTGGTAGTCCA and P13P rev: AGGCCCGGGAACGTATTCAC. The obtained PCR products were directly sequenced on the ABI3500 genetic analyser (ThermoFisher Scientific, USA), using the BigDye Terminator v3.1 Cycle Sequencing Kit (ThermoFisher Scientific, USA), according to the recommendations of the manufacturer.
Parasitology
External and internal organs of the fish were examined microscopically according to Ergens and Lom (1970), Dyková and Lom (2007) and Moravec (2023).
Sampling procedure for histopathology
Tissue samples of skin, eyes, gill, liver, kidney and spleen, taken from ten affected fish and from ten unaffected fish were fixed in modified Davidson’s fixative, embedded in paraffin and sectioned at 5–7 µm. Histological sections were stained with haematoxylin-eosin, by the PAS method (periodic acid-Shiff’s reagent), Gram method, Van Gieson’s staining and Masson’s trichrome staining. The BX53 microscope (Olympus) with the digital camera DP73 (Olympus) was used for microscopic examination and photo documentation.
Haematology
After anaesthesia with Menocain (3-aminobenzoic acid ethyl ester sodium hydrogen sulphate at a concentration of 0.06 g L-1) (Král 1988), blood was drawn by caudal puncture with a non-heparinized syringe. Two microscope slides were prepared for each individual fish, and blood was smeared immediately on microscopic slides and left to dry for 24 h. Smears were fixed in May-Grünwald solution for 3 min and stained with Giemsa-Romanowski solution for 40 min. For each individual, erythrocytes were scored under 100× magnification using the BX53 light microscope equipped with microscope digital camera DP73 (Olympus) to determine the frequency and morphology of the observed erythrocyte lesions.
Results
Clinical and microscopical findings
The disease occurred in September in about 10 % of the stock in raceway fish culture on a commercial fish farm (291 m above sea level). Signs of disease occurred a week from regular transport lasting an hour, after which the fish were not added to a pre-existing culture but instead, they were placed in a new tank. Before being transported, the fish were subjected to parasitological, bacteriological and mycological examination and to virological examination for VHS and IHN, and the results were negative. The clinical signs of moribund fish manifested themselves as anorexia, lethargy and slow swimming on the surface of the water. At necropsy, gross external lesions included unilateral or bilateral exophthalmos, eye haemorrhage and pale gill, and the internal features of lesions included mild hyperaemia over the visceral fat in pyloric region, pale liver, yellow liver, ecchymotic or petechial haemorrhages in liver, enlarged spleen and hyperaemia of the intestinal wall (Figs 1a – g). Histological examination revealed eye oedema; the livers displayed moderate or severe acute haemorrhagic hepatitis, inflammatory reaction around the bile ducts, moderate focal vacuolation of hepatocytes, and congested haemorrhagic spleen with infiltration into visceral fat (Figs 2a-d). Prevalence of the pathological lesions was not uniform. Liver lesions prevailed in 60 % of the fish.
On the primary BA and TSA plates, the bacteria were isolated from eye, liver, kidney and, in one fish, from a caudal peduncle lesion (Fig. 1) in pure culture as sparse to rich cultures, where they formed a smooth colony and had a white colour (Fig. 4). Infection intensity, monitored according to the number of colonies, was not in correlation with the degrees of pathological lesions in organs. Bacteriological examination of the fish without clinical signs was negative. On wet mount examination, the gliding bacteria, which form colonies with rhizoidal edges (flavobacteria), were not observed. Also, the bacteria were not found in imprint preparations and in histological sections as gram- rods.
Blood smears in affected fish showed the presence of erythrocytes with cytoplasmic lesions, whose occurrence in six fish ranged between 60 and 70 % and in four fish between 70 and 90 % (Figs 3a-h). No such lesions were seen in fish with no clinical signs of disease and with a negative bacteriological finding. Eosinophilic cytoplasmic inclusion bodies, characteristic for VEN diagnosis, were not found in the affected and unaffected fish we examined, and, therefore, it was unnecessary to use transmission electron microscopy (TEM) (Amos 1985) for the definitive diagnosis of VEN. Also, there were no single or multiple basophilic bluish cytoplasmic inclusions, which would confirm the erythrocytic inclusion body syndrome (EIBS).
Parasitological findings included occasional incidence of only Trichodina sp. on skin and gills.
Bacteriology
Characteristics of the bacterial strains
The NRL/St 25/203 strain had a typical appearance of coagulase-negative Staphylococcus. It was Gram-positive with spherical cells. Colonies on Columbia blood agar were white and about 0.5 mm in diameter after 48 hours’ incubation at 25 °C. The strain was without alpha-, beta-, and delta-haemolysis.
Phenotypic biochemical characteristics
Erba-Expert software identified the isolate as Staphylococcus warneri with a probability of 99.61 % and T-index of 0.979. The strain was sensitive to ciprofloxacin, ceftarolin, gentamicin, clindamycin, linezolid, oxacillin, rifampicin, tetracycline, and tobramycin. It was resistant to penicillin G and erythromycin. No mecA gen was found. The isolate had no genes for Panton-Valentine leukocidin, enterotoxins SEA–SED, exfoliatins ETA, ETB, ETD, and toxin of Toxic-shock syndrome.
MALDI-TOF mass spectrometry results
MALDI-TOF mass spectrometry identified the isolate as Staphylococcus warneri with score value of 2.27 (rank quality ++).
Discussion
Musharrafiev et al. (2013) reported for the first time the presence of S. warneri that resides in the skin epidermis as a resident commensal of rainbow trout skin. S. warneri was isolated from healthy hatchery trout skin epithelial cells. The purpose of their study was to examine the role of S. warneri as a possible pathobiont for rainbow trout as well as the interactions between S. warneri and Vibrio anguillarum. Their in-vivo experiments showed that S. warneri is not pathogenic to rainbow trout when injected intraperitoneally at high concentrations. However, S. warneri is able to stimulate V. anguillarum growth and biofilm formation on rainbow trout scales.
However, S. warneri may play a role as a causative agent in outbreaks of disease, as demonstrated by Gil et al. (2000) and Metin et al. (2014) in rainbow trout broodstocks. The authors describe ulcerated cutaneous lesions on the fins, exophthalmos, distended abdomen with abundant ascitic fluid and discoloured liver (Gil et al. 2000) or, in chronic course of disease, emaciation, decreased mucus content, grey cloudy appearance on the flank, blistering of the skin surface, erosive lesions on the base of the anal fins, petechial haemorrhage and lysis in muscle and discoloured liver (Metin et al. 2014). This adds to the range of signs we describe to occur in the course of the disease on a rainbow trout farm in autumn. However, salmonids are not the only susceptible group of species: S. warneri was isolated from Coreius guechonoti in China, where the histopathological finding in the affected fish included a substantial inflammatory cell infiltration in the tissues and muscle lesions (Xiao et al. 2022). However, our review of Figure 5 images from these authors indicates that the described liver and muscle lesions are not evident, i.e., they are misdiagnosed. Isolations from the spleen and liver of Siberian sturgeon (Acipenser baerii) and hybrid sturgeon (Huso huso x Acipenser baerii) with co-infection by Shewanella putrefaciens were reported by Rusev et al. (2016). Combined isolations together with Aeromonas salmonicida, Carnobacterium maltaromaticum and Flavobacterium oncorhynchi from a peduncle lesion in koi carp suffering from CEV (carp oedema virus) were reported by Řehulka et al. (2020). All this indicates that the pathogenic role of S. warneri must be given due consideration, especially in farmed salmonid fish where outbreaks of the disease can be attributed to fish farming practices (i.e. handling and other manipulations) (Musharrafiev et al. 2013). The health of homoiothermic vertebrates is also at risk, as documented by a case of bovine abortion (Barigye et al. 2007) and a diseased pig in China (Liu et al. 2020). Cases reported in humans include septic arthritis of the knee (Rodríguez-Montserrat et al. 2018), native valve endocarditis (Yamamoto et al. 2020) and isolates from orthopaedic infections (Campoccia et al. 2010).
All biochemical characteristics of our strain of S. warneri were consistent with data in Manual of Clinical Microbiology 13th ed. (Becker et al. 2023), and with characteristics in Gil et al. (2000) and Metin et al. (2014). Sensitive results of antibiotic survey for S. warneri NRL/St 25/203 found in our study were similar to the results in both articles by Gil et al. (2000) and Metin et al. (2014). Resistance of our S. warneri strain to erythromycin differs from Gil et al. (2000), but not from Metin et al. (2014).
The results of our study and the findings reported by the authors mentioned above show that S. warneri as an opportunistic pathogen for fish may, both alone and in mixed bacterial infections, cause serious disease in transport-stressed individuals. The case description suggests that this might represent a secondary or opportunistic infection associated with immunosuppression due to handling stress (e.g., transport), as already suggested by the results in the limited literature and scarce case reports of S. warneri isolations from clinical cases in fish – together with its known role as an opportunistic pathogen in other animal species and in humans, and its ubiquity in diverse environments. Gross external and internal signs suggest that it would be worthwhile to examine the haematological parameters, including haematocrit values, red blood cell counts and haemoglobin measurements, in the unaffected and moribund fish to see if the latter are actually anaemic. Given that the fish had active bacterial infections, white blood cell counts may also be informative. The insignificant fluctuation of the proportion of the isolated S. warneri germs in relation to the severity of the pathological findings may raise suspicion that other infectious agents, undetected by us, might also be involved. Our haematology results, describing erythrocyte cytoplasmic lesions which manifest themselves as reduction of the cytoplasm and likely membrane destruction, call for virological examination, which however, could not be carried out in our study because the disease had an acute course and the breeder hurried to destroy the diseased fish and prevent further spreading of disease. The results of our study add to the findings presented by the quoted authors and highlight the need to conduct one or more challenge studies in an attempt to fulfil Koch’s or similar postulates. This will contribute to enhancing the health screening of rainbow trout, which is commercially the most important species in intensive salmonid aquaculture in the Czech Republic.